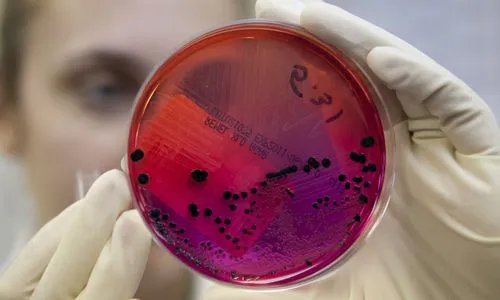

С подозрением на сибирскую язву в Елабуге госпитализировали мужчину

С подозрением на сибирскую язву медики госпитализировали 80-летнего жителя одного из сел Елабужского района, сообщает пресс-служба управления Россельхознадзора по РТ.Пробы мяса говядины и свинины, обнаруженные в морозильнике в доме сельчанина, специалисты отправили для исследования в республиканскую ветеринарную лабораторию. Морозильник с остатками мяса и комнату опечатали и оставили под охраной. Результаты исследований показали, что пробы мяса не содержат возбудителей сибирской язвы. 21 ноября при поступл
С подозрением на сибирскую язву медики госпитализировали 80-летнего жителя одного из сел Елабужского района, сообщает пресс-служба управления Россельхознадзора по РТ.
Пробы мяса говядины и свинины, обнаруженные в морозильнике в доме сельчанина, специалисты отправили для исследования в республиканскую ветеринарную лабораторию. Морозильник с остатками мяса и комнату опечатали и оставили под охраной. Результаты исследований показали, что пробы мяса не содержат возбудителей сибирской язвы.
21 ноября при поступлении пенсионера в больницу у него были высокая температура, воспаления на коже, боли в лимфатических узлах. После исследований первоначальный диагноз не подтвердился. Сейчас больной идет на поправку.
Специалисты управления Россельхознадзора РТ напоминают, что запрещается покупать мясо в местах несанкционированной торговли и без клейма ветеринарно-санитарной экспертизы на туше и ее частях. Нелишне будет поинтересоваться наличием у продавца ветеринарного свидетельства или ветеринарной справки, подтверждающей происхождение мяса, его качество и безопасность, а также благополучие в эпизоотическом отношении местности, из которой оно было привезено.